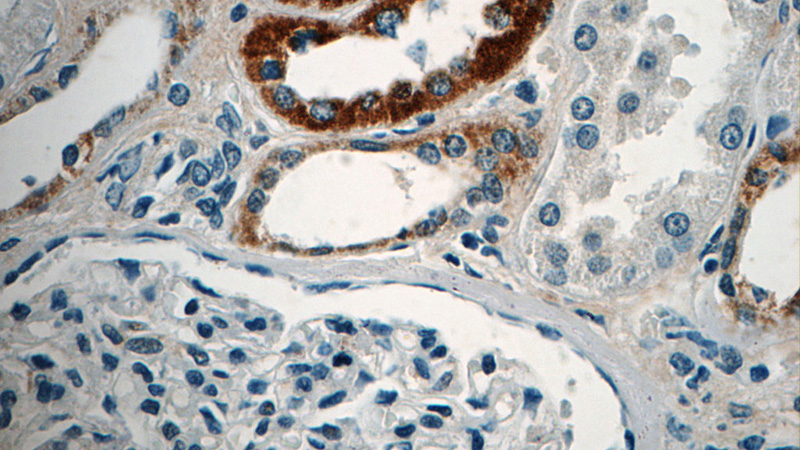
Immunohistochemistry of paraffin-embedded human kidney tissue slide using Catalog No:112372(MAF Antibody) at dilution of 1:50 (under 40x lens)

-
Product Name
MAF antibody
- Documents
-
Description
MAF Rabbit Polyclonal antibody. Positive IP detected in A431 cells. Positive WB detected in A431 cells, A375 cells, K-562 cells. Positive IF detected in A431 cells. Positive IHC detected in human kidney tissue. Observed molecular weight by Western-blot: 48-50 kDa
-
Tested applications
ELISA, IHC, WB, IP, IF
-
Species reactivity
Human,Mouse,Rat; other species not tested.
-
Alternative names
c MAF antibody; cMAF antibody; MAF antibody; Proto oncogene c Maf antibody; Transcription factor Maf antibody
-
Isotype
Rabbit IgG
-
Preparation
This antibody was obtained by immunization of Peptide (Accession Number: NM_005360). Purification method: Antigen affinity purified.
-
Clonality
Polyclonal
-
Formulation
PBS with 0.02% sodium azide and 50% glycerol pH 7.3.
-
Storage instructions
Store at -20℃. DO NOT ALIQUOT
-
Applications
Recommended Dilution:
WB: 1:200-1:2000
IP: 1:200-1:2000
IHC: 1:20-1:200
IF: 1:50-1:500
-
Validations

WB result of Catalog No:112372.

A431 cells were subjected to SDS PAGE followed by western blot with Catalog No:112372(MAF antibody) at dilution of 1:500

IP Result of anti-MAF (IP:Catalog No:112372, 4ug; Detection:Catalog No:112372 1:500) with A431 cells lysate 2000ug.
Immunohistochemistry of paraffin-embedded human kidney tissue slide using Catalog No:112372(MAF Antibody) at dilution of 1:50 (under 40x lens)

Immunofluorescent analysis of (10% Formaldehyde) fixed A431 cells using Catalog No:112372(MAF Antibody) at dilution of 1:50 and Alexa Fluor 488-congugated AffiniPure Goat Anti-Rabbit IgG(H+L)
-
Background
MAF, also named as c-Maf, belongs to the bZIP family and Maf subfamily. MAF acts as a transcriptional activator or repressor. It is involved in embryonic lens fiber cell development. MAF increases T cell susceptibility to apoptosis by interacting with MYB and decreasing BCL2 expression. Together with PAX6, it transactivates strongly the glucagon gene promoter through the G1 element. MAF activates transcription of the CD13 proximal promoter in endothelial cells. It is involved in the initial chondrocyte terminal differentiation and the disappearance of hypertrophic chondrocytes during endochondral bone development. When overexpressed, MAF represses anti-oxidant reponse element (ARE)-mediated transcription. It is involved either as an oncogene or as a tumor suppressor, depending on the cell context. A chromosomal aberration involving MAF is found in some forms of multiple myeloma (MM). Defects in MAF are the cause of cataract pulverulent juvenile-onset MAF-related (CAPJOM). Defects in MAF are the cause of cataract congenital cerulean type 4 (CCA4). The antibody is specific to MAF.
Related Products / Services
Please note: All products are "FOR RESEARCH USE ONLY AND ARE NOT INTENDED FOR DIAGNOSTIC OR THERAPEUTIC USE"
